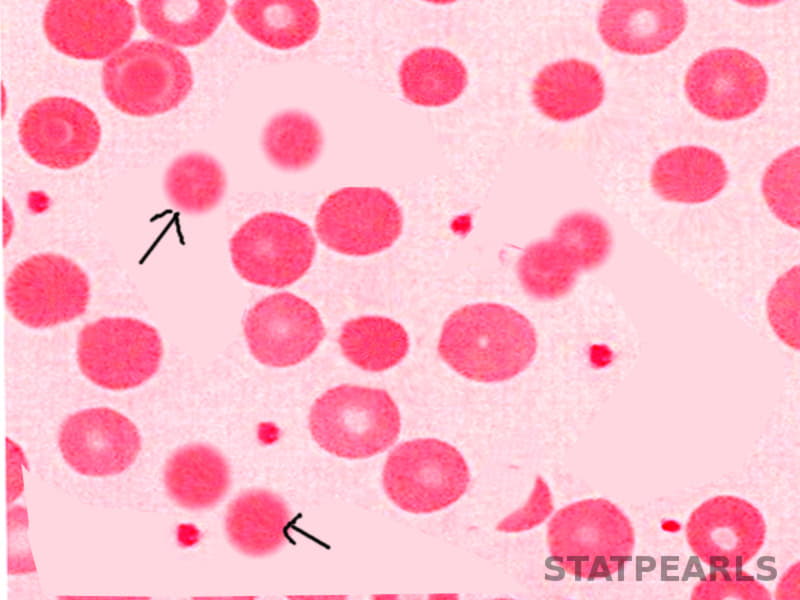

Herediter Sferositoz, eritrosit yüzeyi proteinlerinde ki azalmaya bağlı olarak düz şekilli eritrositlerin küre şeklini almasıyla oluşan bir yüzey bozukluğudur. Kalıtsal sferositoz olarak ta bilinir. Bu hastalık ortaya çıktığında Spektrin ve Ankrin adı verilen eritrosit yüzey proteinlerinin sayısı azalmaktadır. Protein sayısı azaldıkça eritrosit yüzeyindeki lipidler mikroveziküler hal olarak uzaklaşmaktadır. Otozomal Dominant seyirli kalıtsal bir hastalıktır. Bu yazımda herediter sferositoz hastalığı için “HS” kısaltmasını kullanacağım.
Herediter Sferositoz Nedir?
Herediter sferositoz kojenital hemolitik anemi hastalıklarının en yaygın nedeni olarak bilinir ve ilk defa 1900’lü yılların başında Oskar Minkowsky tarafından tanımlanır. Eritrositler normalde bilinen bir şekilleri vardır. Bu şekillerini morfoloji stabiliteyi sağlayan genetik kodlar sayesinde korurlar. Bu genetik kodlarda ortaya çıkan mutasyonlar nedeniyle eritrositler bikonkav şekillerini koruyamazlar. Dolayısıyla eritrosit şekil bozuklukları ortaya çıkar. (Kaynak No:1)
Temel olarak kırmızı kan hücresinin zarını oluşturan bir ya da daha fazla proteinde kusur ve eksiklik ile karakterizedir. İstatistiksel olarak Kuzey Avrupa kökeni olan insanlarda 2000’de 1 gibi bir prevalansa sahiptir. (Kaynak No:2) Görülen vakaların yüzde 72’i baskın olarak kalıtılırken geriye kalan yüzde 25 dilim ise çekinik ve denovo mutasyonlardan ibarettir.
Herediter Sferositoz Neden Olur ?
HS’un neden olduğunu anlamak için öncelikle vücudun normal fonksiyonlarına kısaca değinelim. Normalde dalağın eritrositler dalaktan geçerken normal olmayanları ve bozuk olanları ayırt edip uzaklaştırmak gibi önemli bir görevi bulunmaktadır.
Yukarıda bahsettiğimiz gibi düz olması gerekirken küre şeklini alan eritrositler dalaktan geçerken yakalanırlar. Dalak bu eritrositlerin normal olmadığını anlar ve yok edilmek üzere gerekli süreci başlatır.
HS hastalarında kandaki eritrositler yani alyuvarlarımız sürekli olarak dalak tarafından yıkılmaya programlanırlar. Eritrositler yıkıldıkça miktarı azalır ve hemolitik anemi ortaya çıkmaya başlar. Normal alyuvarların ömrü 3-4 ay civarındayken HS’de en fazla 1 ay yaşarlar .
Normal eritrositlerin HS’deki eritrositlerden farkı bikonkav şekilli olması ve yüksek plastisiteye sahip olmasıdır. Bu şekil bozuklukları ve genetik faktörler hastalığın temel nedenini oluştururlar.
Herediter Sferositoz Belirtileri
Herediter sferositoz hastalığının klinik formları incelendiğinde hafif şiddette HS’den fulminant HS’ye kadar çok geniş spektrumlu olduğu görülüyor. HS hastaların sıklıkla nefes alma güçlüğü, çabuk yorulma, nabız sayısında artma, sarılık gibi sıkıntıları olur. Akılda kalıcı olması açısında sık görülen bu bulgular 5S olarak ifade edilir :
- Solunum Sıkıntısı
- Safra Taşları
- Sarılık
- Soluk Beniz
- Splenomegali
Hastalarda dalak tarafından düzenli olarak eritrositler yıkıldığı için normalde eritrosit içinde bulunan bilirubin maddesi dışarı çıkar ve kana karışır. Doğal olarak bilirubinin miktarı sürekli artar. Bilirubin fazlalığı sarılık oluşumuna sebebiyet verir. Sarılıkta hastalarda deride özellikte yüz derisinde belirgin bir renk değişikliği olur.
Herediter Sferositoz Teşhisi
Sarılık gibi bulguların varlığıyla beraber ilk önce dalak büyümesi kontrol edilmelidir.Dalak büyümesi Kalıtsal Sferositoz lehine güçlü bir bulgudur. Tanısal anlamda ailesel hikayede çok önemlidir. Daha önce ailenizde bir kişide bu hastalığın olması sizde de bu hastalığın çıkma ihtimalini kuvvetlendirecektir.
HS Tanısı Nasıl Konulur?
Herediter sferositoz tanısı, retikülosit sayımı, tam kan sayımı, bilirübin ölçümü, hastanın kliniği ve diğer laboratuvar sonuçlarının beraber değerlendirilmesi sonucunda koyulur.
Dalak HS hastalarında eritrositleri yıktığı için vücutta buna karşılık yeni eritrosit üretimini artıracaktır. Yavru eritrositlerin adı Retikülosit’tir. Doğal olarak retikülosit miktarı artacaktır. Hastalık ağırlaştıkça dalak daha çok yıkım yapacak vücutta daha çok retikülosit üretecektir.
Bolton-Maggs ve arkadaşları tarafından hazırlanan “Herediter Sferositoz Kılavuzu” incelendiğinde hemoglobin değeri 8 g/dL’den daha düşük olan hastaların HS şiddetinin yüksek olduğu, 8 ila 10 g/dL arasında hemoglobin değerine sahip hastalarda orta şiddette hissedildiği, 10 g/dL üstü hastalarda ise hafif şekilde hissedildiği bilgisinin geçtiği görülmektedir. (Kaynak No:3)
Herediter Sferositoz Hangi Hastalıklarla Karışabilir ?
HS hastalığının ayırıcı tanısı yapılacağı zaman karışabileceği birçok kırmızı kan hücresi hastalığı akla gelmektedir. Genelde karışabildiği durumları ve hastalıkları şöyle sıralayabiliriz :
- Masif Kan Transfüzyonları
- Hemolitik Anemiler
- Kalıtsal Piropoikilositoz
- Kan Uyuşmazlıkları
- Ciddi hipofosfatemiler
Otoimmün hemolitik anemi hastalığı hemolize sebebiyet veren hastalıklardan biridir. HS’nin ayırıcı tanısı çok dikkatli yapılmalıdır.
Herediter Sferositoz Komplikasyonları
Herediter sferositoz hastalarının ortalama ve istatistiksel olarak yüzde 50’si anemi şikayetiyle, %15’i splenomegali ve sarılık şikayetleriyle başvurur. (Kaynak No:4) Splenomegalisi olan hastalar zamanında ve yeterli bir şekilde müdahale almadığında sepsis riski ile karşı karşıyadır.
- Bilirubin artışının tetiklediği safra taşı oluşumları
- Folat eksikliğine bağlı yapısal bozukluklar
- Kemik dışında kan üretimi
- Vücudun belli yerlerinde ülserler görülebilir.
Bunlara ek olarak megaloblastik anemi krizi görülebilir ve folat tedavileri ile rahatlama sağlanır.
Herediter Sferositoz Tedavisi
Temel olarak HS tedavisi hastanın yaşam kalitesini maksimuma çıkarmaya, HS komplikasyonlarında uzak durmaya ve var olan semptomları giderme şeklinde yapılır. Pediatrik hastalarda hemoglobin seviyeleri 7 ile 8g/dL ‘nin üzerinde tutulmaya çalışılır. Yenidoğanlarda transfüzyona ihtiyaç duyulduğunda hastaya göre karar verilmelidir. (Kaynak No:5)
Splenektomi yapılan çoğu hastada semptomlar bariz bir eşkilde gerileme göstermektedir. Şiddetli HS geçiren hastalarda splenektomi iyi bir seçenek olarak değerlendirilirken orta ve hafif şiddette HS geçiren hastalarda ise splenektomi kararı dikkatli bir şekilde verilmelidir. (Kaynak No:6)

Her Kalısal Sferositozlu hastaya splenektomi yani dalak çıkarılması uygulanacak diye bir kaide yoktur. Doktor çoğu zaman farklı tedaviler önermekte ve mecbur kalınan durumlarda splenektomi önermektedir.
Dalağın çıkarılması şu durumlarda gündeme gelmektedir:
- Aşırı büyümüş dalak
- Anemiyle beraber egzersiz kapasitesinin azalması
- Ciddi anemi durumlarında
Hemoliz görülen hastalarda hemolizi telafi etmek amacıyla eritropoetik aktivitede artış gözlenir. Bu artış folat tüketimini hızlandırır. Dolayısıyla bu hastalara yeterli seviyede folat desteği sağlanmalıdır. (Kaynak No:3)
HS’ nin tedavisi Uluslararası Herediter Sferositoz Kılavuzuna göre 3 aşamalıdır.
1.aşama Eritrosit Transfüzyonu yani vücudunuza dışarıdan alyuvar verilerek desteklenmesidir.Transfüzyonun derecesi hastalığın ciddiyetine göre değişim göstermektedir.
2.aşama Splenektomi yani dalağınızın vücudunuzdan çıkarılması işlemidir.Eritrosit yıkımlarının önüne geçilemezse eritrositleri yıkan dalağı ortadan kaldırmakta bir çözümdür.
3.aşama Folik Asit Tedavisidir. Eksik olan folik asitin yerine konarak eritrosit üretimi desteklenir.Genelde ciddi vakalarda kullanılır.
Kaynakça:
- Red cell membrane disorders – PubMed (nih.gov) Erişim Tarihi: (11.09.2021)
- Hereditary spherocytosis – PubMed (nih.gov) Erişim Tarihi: (11.09.2021)
- Guidelines for the diagnosis and management of hereditary spherocytosis–2011 update – PubMed (nih.gov) Erişim Tarihi: (11.09.2021)
- Hereditary spherocytosis in 100 children – PubMed (nih.gov) Erişim Tarihi: (11.09.2021)
- [Hereditary spherocytosis. Review. Part II. Symptomatology, outcome, complications, and treatment] – PubMed (nih.gov) Erişim Tarihi: (11.09.2021)
- Hereditary Spherocytosis – Diagnosis, Surgical Treatment and Outcomes. A Literature Review – PubMed (nih.gov) Erişim Tarihi : (11.09.2021)
- [Figure, Hereditary Spherocytosis. Image courtesy S Bhimji MD] – StatPearls – NCBI Bookshelf (nih.gov) Erişim Tarihi: (11.09.2021)
Aklınıza takılanları veya merak ettiklerinizi yorum bölümünden sorabilirsiniz. Cevap vermekten mutluluk duyacağım. Yorumlarınızı bekliyorum.
(Bu yazı ilk defa 26 Mayıs 2017 tarihinde yazılmıştır. Ardından 11 Eylül 2021 tarihinde güncellenmiştir.)

Hocam merhaba kızım 2.5 yasinda.herediter sferositoz tanısı konuldu.hgb değeri 9 ile 10 arasinda.haftada 1 adet folit asit tedavisine başladık. Folit asitte başlamak doğru bir karar mi
Hocam merhaba ben 29 yaşında. Bu ameliyati oldum gözümüzde buyuttugumuz bir ameliyatmis normal safra kesesi ameliyatından bir farkı yok gibi aşılarımi oldum grip olduğumda çok rahat atlatıyorum covid geçirdim ayakta onun için ameliyat safhasına gelenler için söylüyorum inanın yeniden doğmuş gibi olacaksiniz
Merhba 2 oglumdada benden geçen bu hstlik var daha. Bugün hstaneden çıktık hemoglbin 5 düştü kan verildi.hematoloji Niğde’de olmadigi iciin ankaraya gitmem gerekiyor.beni çok zorluyor sürekli yıkılıyor kanları Allah’ım herkese şifa versin benim çocuklarında amin
Merhaba,
Benim kızım 13 yaşında 7 yaşında bu tanı konuldu. Şehrimizde çocuk hematoloji doktoru olmadığı için kontrollerde zorlanıyoruz. Kızım sürekli yorgun ve uykulu. Bu hastalığın böyle bir etkisi var mı acaba. Yorgunluk ve uyku yüzünden ders çalışamıyor. D vitamini eksikliği olduğu için sadece onu verdi doktor. Başka ilaç kullanmıyor. Safra taşı ve dalak büyüklüğü var. Bilgi verirseniz sevinirim.
Merhabalar Meliha Hanım, öncelikle geçmiş olsun.
Bazı kan değerlerinde düşüklük olması durumunda uyku hali, yorgunluk ve sürekli halsizlik görülebilir ancak bu durumun tespit edilebilmesi için mutlaka hastamızı muayene olmaya götürmeliyiz.
Sağlıklı ve mutlu günler dilerim.
Hocam merhaba.kizim 2.5 yaşında herediter sferositoz tanısı konuldu.hgb değeri 9 ile 10 arasında doktor folit asit başladı haftada 1 adet bu tedavi doğrumu.
merhaba doktor bey 17 yaşındaki kızımda var bu hastalık su anda haftada bir folbiol kullanıyor. yeni folik asit miktarını ölçtürdügümde sınırın üç puan üstünde yani folik asit 20 çıktı ilaca devam etmemiz gerekir mi birde biliribün biraz yüksek çıkıyor nasıl düşürebiliriz. teşekkürler.
İki aylık prematüre bebegim de bu hastalığın olabileceği söylendi. kontrollerde net tanı konulacak ama periferik yayma ve diğer tahliller sonucunda büyük.ihtimalle bu hastalık dendi.hastaligin net tanısı ve seyir seviyesi belli olunca tedavi başlanacak.merak ettiğim bu kızımın yaşamını nasıl etkiler.Çok küçük çünkü…Teşekkür ederim simdiden
Öncelikle çok geçmiş olsun ben 21 yaşında bu taniyi aldım ve 29 yaşında ameliyat oldum ailede benden önce kimsede yoktu belki de vardı farkında değillerdi rakiplerinizi yaptırın ameliyattan korkmayın 1 günde ayağa kalktım haftasına arkadaşlarımla kahve içmeye dışarı gittim tedavisi çaresi var Allah çaresiz vermesin kızınız şimdi nasıl ?
Merhaba Yasemin hanım.21 yaşından önce bir belirti yokmuydu
DoktoruumTaninolarak hereditersferositoz dedi vesadece folbiol diye bi ilqc verdi billurubin 3.1. Genetik kan testlerim negatif ve dalak 17.5 cm hemoliz baslangici %0.50 hasta %0,46 kontrol hemoliz bitisi %0,42 hadta %0.37 kontrol hgb 11.7 hct 35.5 busonuclar dogrultusunda ilac olrak bu yeterlimi napmaliyim acaba TESEKKUR ederim…
Merhaba Mustafa Bey, öncelikle geçmiş olsun.
Sonuçlarınız doğrultusunda başlanmış olan ilacınızı kullanın ve düzenli olarak kontrollere gidin. Düzenli kontroller neticesinde tedaviden fayda görüp görmediğiniz, tedavinin yeterli olup olmadığı belli olacaktır.
Sağlıklı günler dilerim.
Doktor bana dalagimin alınmasını önerdi ama ben farklı ilaç tedavisi istiyorum. Sinirdaymisim. Dalagimin alınmasını istemiyorum. Oneriniz nedir?
Öncelikle geçmiş olsun Ayşe Hanım.
Herediter sferositoz un ileri evrelerinde bazen splenektomi yani dalağın çıkarılması kaçınılmaz olabiliyor. Doktorunuzla beraber karar vermelisiniz.